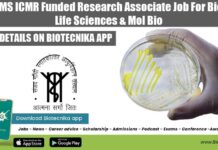
SGPGIMS ICMR Funded Research Associate Job For Biotech, Life Sciences & Mol Bio SGPGIMS Research Opening 2022

Earn Fellowship of Rs. 35,000 pm as Post-Doctoral Fellow @ SRM University in DNA...
SRM University is one of the top ranking universities in India with over 38,000 students and more than 2600 faculty across all the campus,...
Exclusive Govt R&D Openings @ Biologics characterization facility (BCF) at Bangalore Life Science Cluster,...
Technology Assistant/Associate position in Biologics characterization facility (BCF) at Bangalore Life Science Cluster, Bangalore
Centre for Cellular and Molecular Platforms (C-CAMP), is a Dept. of...
Grab Salary of Rs.28,000 plus 30% HRA as Research Fellow @ Amity University
Amity University is part of the not-for-profit Amity Education Group with over 2 decades of excellence that includes 6 world-class universities, 17 schools &...
Research Associate (RA) vacancy @ NII | Earn upto Rs. 38,000/- pm
The National Institute of Immunology (NII) is committed to advanced research addressing the basic mechanisms involved in body's defence to identify modalities for manipulation...
Work as a Research Executive @ Bharat Serums and Vaccines Limited
Bharat Serums And Vaccines Limited (BSV) is one of the fastest growing biopharmaceutical companies in India and has been ranked amongst the to Indian...
Amity Institute of Microbial Biotechnology invites Applications for the Post of Young Professional
Amity University is part of the not-for-profit Amity Education Group with over 2 decades of excellence that includes 6 world-class universities, 17 schools &...
Multiple R&D vacancies for Biofuel & miRNA Related Projects @ ICGEB
The ICGEB is an international, nonprofit research organization. Established as a special project of UNIDO, it became fully autonomous in 1994 and now counts...
Applications invited for 10 Assistant Professors posts @ KAU
Kerala Agricultural University (KAU) is the primary and the principal instrumentality of the Kerala state in providing human resources, and skills and technology, required...
Work as JRF at National Institute For Research in Reproductive Health
National Institute for Research in Reproductive Health (NIRRH), formerly known as Institute for Research in Reproduction is a premier research institute of the Indian...
Microbiology candidates work as Project Assistant @ NEERI
National Environmental Engineering Research Institute (NEERI), a constituent laboratory of CSIR endeavours to provide Leadership in environmental science and engineering for sustainable development. NEERI...
Only Half the Genomes in Newest Human Stem Cell Creation
Scientists for the first time have generated a type of embryonic stem cell that carries a single copy of human genomes rather than the...
Tiny Inexpensive Microbial Fuel Cell turns Human Waste into Electricity
A new kind of fuel cell that can turn urine into electricity could revolutionize the way we produce bioenergy, particularly in developing countries. The...
50 US Cities at Potential Risk from Zika Virus
Factors that can combine to produce a Zika virus outbreak are expected to be present in a number of U.S. cities during peak summer...
How HBV’s X protein Circumvents Our Defence Systems
The hepatitis B virus (HBV), which is up to 100 times more infectious than HIV, is primarily transmitted through blood or other bodily fluids....
Focusing on High Quality, Cheap Mini Microscopy
Researchers from Brigham and Women's Hospital (BWH) and MIT have combined an innovative microscopy technique with a methodology for building inexpensive mini-microscopes, allowing them...